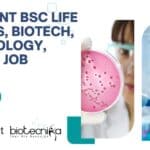
Cognizant BSc Life Sciences, Biotech, Microbiology, Biochem Job Opening, Apply Now Cognizant BSc Life Sciences

Home Search
biology - search results
If you're not happy with the results, please do another search
Avantor Job For Biotech, Biochem, Microbiology : 0-6 Months Experience Required | Apply Online
Avantor Biotech Freshers Job. Avantor Associate Job, Biotechnology, Biochemistry, Microbiology Apply Online. Graduate Life Sciences Jobs. Interested and eligible candidates can check out the...
Labcorp MSc Biotech, Biochem, Zoology & Microbiology Job Opportunity, Apply Online
Labcorp MSc Biotech, Biochem, Zoology & Microbiology Job Opportunity, Apply Online
Labcorp MSc Biotech, Biochem, Zoology & Microbiology Job Opportunity, Apply Online. Biotech, Biochem, Zoology...
Cognizant BSc Life Sciences, Biotech, Microbiology, Biochem Job Opening, Apply Now
Cognizant BSc Life Sciences, Biotech, Microbiology, Biochem Job Opening, Apply Now
Cognizant BSc Life Sciences, Biotech, Microbiology, Biochem Job Opening, Apply Now. Life Sciences (Biotech,...
Labcorp Biochem, Biology Senior Proposal Associate (Home based) Job Opening
Labcorp Biochem, Biology Senior Proposal Associate (Home based) Job Opening
Labcorp Biochem, Biology Senior Proposal Associate (Home based) Job Opening. Biochem, Biology job opening. Labcorp...
Pepsi India R&D Spec Writing Role For BS, MSc Food Tech, Microbiology Candidates
Pepsi India R&D Spec Writing Role For BS, MSc Food Tech, Microbiology Candidates
Pepsi India R&D Spec Writing Role For BS, MSc Food Tech, Microbiology...
NIAB Immunology, Biotech, Biochem, Microbiology, Bioinformatics Project Jobs, Apply Online
NIAB Immunology, Biotech, Biochem, Microbiology, Bioinformatics Project Jobs, Apply Online
NIAB Immunology, Biotech, Biochem, Microbiology, Bioinformatics Project Jobs, Apply Online. National Institute of Animal Biotechnology...
Pepsi Microbiology, Food Science, Food Tech Job Opportunity For BSc, MSc Candidates
Pepsi Microbiology Job, Food Science, Food Tech Job Opportunity For BSc, MSc Candidates
Pepsi Microbiology Job, Food Science, Food Tech Job Opportunity For BSc, MSc...
Clarivate MSc Life Science, Biotech, Microbiology & Biophysics Job Opening, Apply Online
Clarivate MSc Life Science, Biotech, Microbiology & Biophysics Job Opening, Apply Online
Clarivate MSc Life Science, Biotech, Microbiology & Biophysics Job Opening, Apply Online. MSc...
DNV India In-Vitro Diagnostic Assessors Role For Biochem, Biology & Microbiology Candidates
DNV India In-Vitro Diagnostic Assessors Role For Biochem, Biology & Microbiology Candidates
DNV India In-Vitro Diagnostic Assessors Role For Biochem, Biology & Microbiology Candidates. In-Vitro...
IBAB Admission Open 2023 – M.Sc. In ‘Big Data Biology’ – Applications Invited
IBAB Big Data Biology MSc Admissions 2023 Open - Applications Invited
ADMISSION OPEN
M.Sc. in 'Big Data Biology'
The M.Sc. programme in Big Data Biology will be...
Govt NCT Delhi BSc Project Vacancy at ILBS – Biotech, Biochem, Life Sciences &...
BSc Project Vacancy at ILBS - Biotech, Biochem, Life Sciences & Microbiology Apply
BSc Project Vacancy at ILBS - Biotech, Biochem, Life Sciences & Microbiology...
Govt of Delhi ILBS Project Job For MSc Biotech, Biochem, Life Sciences & Microbiology
MSc Project Vacancy at ILBS - Biotech, Biochem, Life Sciences & Microbiology Apply
MSc Project Vacancy at ILBS - Biotech, Biochem, Life Sciences & Microbiology...
Givaudan Microbiology, Food Tech Quality Systems Specialist Job, Apply Online
Givaudan Microbiology, Food Tech Quality Systems Specialist Job, Apply Online
Givaudan Microbiology, Food Tech Quality Systems Specialist Job, Apply Online. University degree in Chemistry, Microbiology,...
Chittaranjan National Cancer Institute (CNCI) MSc Biology & Life Sciences JRF Jobs, Applications Invited
CNCI Biology JRF Jobs Opening - Life Sciences Can Also Apply
CNCI Biology JRF Jobs Opening - Life Sciences Can Also Apply. Chittaranjan National Cancer...
Syngene Clinical Flow Cytometry Job For MSc, MTech Biology, Biotech & Biochem Candidates
Syngene Clinical Flow Cytometry Job For MSc, MTech Biology, Biotech & Biochem Candidates
Syngene Clinical Flow Cytometry Job For MSc, MTech Biology, Biotech & Biochem...